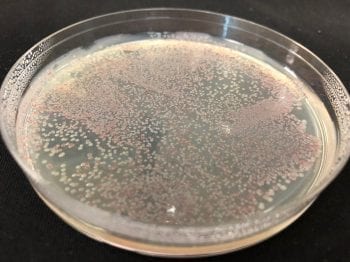
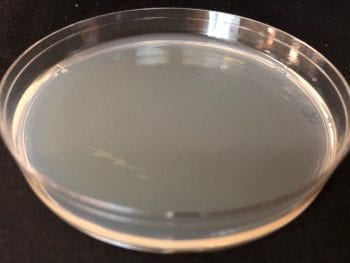

Updated September 3, 2019
Did you just perform a search for "pink mold in shower", "pink shower mold" or "pink mold shower"? Learn more about that pesky pink residue in your shower and how to get rid of it with our tips for removal and prevention.
Pink Shower Mold: What is it?
This pink mold you've found growing on your shower curtain, or in your toilet is not actually mold at all; in fact, it's a Gram-negative bacteria that is scientifically known as Serratia marcescens.
The pink colour is from a pigment (prodigiosin) produced by Serratia marcescens under the right growing conditions.
Serratia marcescens is commonly referred to as “pink mold” or “pink mildew” but it is bacteria causing those irritating pink stains in the bathtub and on your shower head.
What Does Pink Shower Mold Look Like?
Pink shower mold usually appears as a slimy build-up, though it does not always appear to be specifically pink.
The bacteria get their colour from a red pigment that is produced at room temperature. Depending on the growing conditions, the resulting color can range from salmon pink to orange or even blood red.
[caption id="attachment_2931" align="aligncenter" width="600"]

Pink mold on shower head
Where Does Pink Mold Grow?
The bathroom is the perfect place to find Serratia marcescens because it thrives in moist environments. It needs dampness, mineral deposits, and warm temperatures to grow.
Inside of the bathroom, you are most likely to notice pink residue in the shower which is why it is often referred to as "pink shower mold".
The shower is the perfect place for these bacteria to grow as they can feed on the mineral deposits left behind by soap scum and the fatty deposits in personal hygiene product residue.
"Pink shower mold" is most likely to spread when there is excess moisture in the air, allowing the bacteria to become airborne and travel.
[caption id="attachment_2936" align="aligncenter" width="768"]

"Pink Mold" on shower curtain liner
Associated Health Risks
Although this type of bacteria is not as dangerous as black mold, a variety of potential health hazards are linked to exposure to pink shower mold.
While it is harmless to most healthy people that come into contact with it externally, a Serratia marcescens infection can cause various health complications if it enters the body, either through the eyes or an open wound.
The severity and likelihood of these complications increases in elderly people, young children, and individuals with compromised immune systems.
Household pets can also be at risk.
Potential health risks to high-risk individuals include:
- UTI’s (Urinary Tract Infections) and Bladder Infections
- Breathing Difficulties
- Septicemia (Blood Poisoning)
- Endocarditis
- Pneumonia
- Gastrointestinal Ailments
- Osteomyelitis (Bone Infection)
- Infection of Open Wounds or Sores
- Meningitis
How to Get Rid of Pink Bacteria in Shower
Despite "pink shower mold" not being the most hazardous microbe out there, it is still in your best interest to remove it as soon as you see buildup beginning to form.
Spraying a diluted solution of bleach will kill the bacteria and lighten the pink stain. However, to provide a longer-lasting effect, the area will need to be scrubbed down. This gets rid of the underlying minerals and soap scum that the bacteria love to feed on.
To Scrub Down:
Step 1: Suit Up in Protective Gear
To protect yourself from unnecessary exposure to the Serratia marcescens shower bacteria, wear a pair of protective glasses and rubber gloves during your cleaning.
Step 2: Mix Up
Mix ½ cup of baking soda with 1 tablespoon of dishwashing liquid and add small amounts of water to the mixture until it forms a runny paste.
Step 3: Scrub Up (and Down)
Dip a nylon-bristled scrub brush into the paste and vigorously scrub your shower tiles, paying special attention to the grout between the tiles.
Step 4: Rinse Up
Use the removable shower head (if your shower has one) or a small bucket to thoroughly rinse the shower. You can also use a squeegee or wet towel to do so, ensuring all the leftover paste is washed away cleanly.
A Few More Tips
- Drying your shower after each use (with a towel or squeegee) can help prevent mold regrowth
- Washing your shower curtains once a month (check if they are machine washable, then run them through a gentle cycle with warm water) can effectively remove pink mold from one of its’ favourite living spaces
- Turn on your bathroom’s exhaust fan before you shower and leave it on for 20 minutes after your shower to help dry out the air in the bathroom
- Repair shower head leaks, dripping faucets, and running toilets as these common problems provide a constant source of moisture, perfect for bacterial growth
How Ultra-Fresh Antimicrobial Additives Can Help
Ultra-Fresh is commonly used by manufacturers of home products to protect materials against the unwanted effects of microbial growth.
End-use items such as Target shower curtain liners and Novaform memory foam bathmats with Ultra-Fresh antimicrobial technology help keep products free from stains and odors caused by bacteria, mold, and mildew.
[caption id="attachment_2946" align="aligncenter" width="550"]

Target shower curtain liner treated with Ultra-Fresh antimicrobial technology prevents pink staining bacteria from growing on the liner.
Check out some of the companies and brands we work with.
How Does Ultra-Fresh Work to Prevent Pink Staining Caused by Bacteria
The photos below demonstrate how an antimicrobial treated product prevents staining by bacterial growth from happening.
Two shower curtain liner samples, one treated with Ultra-Fresh antimicrobial and another without, were tested using ISO 22196.
The same amounts of bacteria (Serratia marcescens) were added to each sample and then incubated for 24 hours.
Afterward, both samples were assessed to determine how many bacteria were remaining.
As seen in the below photos, heavy amounts of pink coloured bacteria were recovered from the untreated shower curtain liner sample. In contrast, no bacteria were recovered from the antimicrobial treated shower curtain liner.
[caption id="attachment_3372" align="alignleft" width="350"]
Bacteria recovered from untreated shower curtain liner
[caption id="attachment_3378" align="alignright" width="350"]
No bacteria found on Ultra-Fresh antimicrobial treated shower curtain liner.
The chart below demonstrates how an antimicrobial treated shower curtain liner performs over time and after use.
The same number of bacteria were added to a shower curtain with antimicrobial treatment, and also a liner without antimicrobial treatment.
As per the ISO 22196 test method, the samples were incubated for 24 hours at 70F/21C. Afterward, the number of bacteria remaining was determined.

The bacteria on the untreated shower curtain liner grew exponentially (from about 50,000 to almost 500,000!).
However, the Ultra-Fresh treated antimicrobial shower curtain liner, had 99.9% fewer bacteria as compared to the untreated liner after the same time period.
Therefore, the conclusion is very simple: fewer bacteria = less pink staining.
The addition of antimicrobial technology delivers a product that prevents or reduces stains caused by bacterial growth.
Clean or Replace?
There comes a point in every product's life when no amount of cleaning can return it to a cleanliness level appropriate for reuse.
If you are using a product that does not contain an antimicrobial, you'll need to throw it out and replace it every so often, depending on how much it gets used.
If you are using an antimicrobial treated product, the end-use life becomes considerably longer, especially when cleaned routinely.
An antimicrobial treated product is a huge win for the environment since items are thrown out less frequently due to odours, staining, or material breakdown.
In addition, since products aren't replaced as often, antimicrobial treated goods are beneficial to consumers' bank accounts.
Note: Ultra-Fresh is not intended to create a healthier environment or to cover up an existing moisture issue in your home. Antimicrobial product protection prevents odors, staining, and deterioration of the product itself.
Learn more about us or contact us for more information.
More Interesting Reads:
- Difference Between Antimicrobial and Antibacterial
- Shocking Reasons why There is Mold in Your Dishwasher
- Mold or Mould: What is the Difference?
- More blog articles...